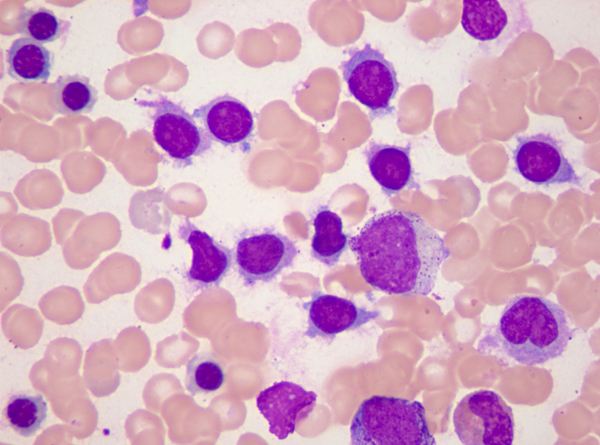
p data-id="gnwlxbn6yd">毛细胞为感受 a targ

毛细胞图片

(第九期)
图片尺寸297x320
显微镜下的内耳毛细胞
图片尺寸381x552
典型病例分析毛细胞白血病
图片尺寸1310x500
有可能是毛细胞吗?
图片尺寸4032x3024
一例由外周血涂片辨识出的毛白
图片尺寸1000x971
造成大量毛细胞死亡(过度刺激所造成的代谢超负荷,也
图片尺寸300x448
谈谈常听音乐人的声损伤
图片尺寸600x444
p data-id="gnwlxbn6yd">毛细胞为感受 a targ
图片尺寸600x445
听毛细胞
图片尺寸640x420
比例高达80%,其中少许细胞形态跟变异型毛细胞(见图
图片尺寸599x486
毛细胞白血病
图片尺寸460x307
2019年广西临床形态学检验室间质量评价样本(第三次)
图片尺寸870x649
基因疗法,失聪者的福音
图片尺寸300x229
细胞美图秀
图片尺寸908x615
为什么连续转圈之后会感觉天旋地转
图片尺寸500x366
这个几乎100可预防的听力损失你知道吗
图片尺寸640x356
基因有缺失或突变,就会通过影响毛细胞的发育和功能等
图片尺寸640x501
【求助】悬浮细胞培养状态很差,细胞成团,细胞上有
图片尺寸5184x3456
干细胞再生有毛的皮肤
图片尺寸1440x1599
多图│教您识别毛细胞白血病
图片尺寸620x620